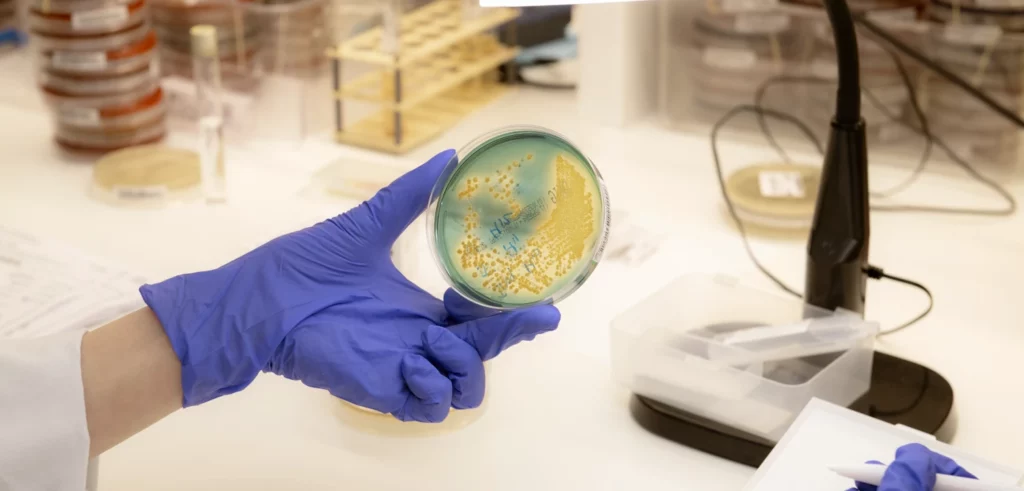

Le Conseil scientifique : une instance au cœur de la mission de la Fondation de l’AP-HP
La Fondation de l’AP-HP soutient la recherche médicale et paramédicale conduite au sein de l’AP-HP, le premier groupe hospitalier universitaire d’Europe. Pour exercer pleinement cette mission, elle s’appuie sur une instance d’expertise indépendante : le Conseil scientifique.
Composé de personnalités scientifiques reconnues à l’échelle internationale, le Conseil scientifique rassemble des experts issus de diverses spécialités médicales, sélectionnés pour leurs compétences et leur capacité à représenter la diversité des disciplines. C’est une instance paritaire : la parité est un critère déterminant dans la sélection de ses membres.
Ses membres sont désignés pour un mandat de quatre ans, renouvelable une fois. Le ou la président(e) du Conseil est élu(e) parmi ses pairs.
Les missions du Conseil scientifique
Le Conseil scientifique accompagne et conseille le Conseil d’administration de la Fondation de l’AP-HP dans le domaine de la recherche et de l’innovation. Il se réunit en règle générale quatre fois par an pour :
- Participer à la définition des orientations scientifiques de la Fondation
- Piloter les programmes de soutien à la recherche médicale et paramédicale soutenus par la Fondation
- Valoriser les talents médicaux et paramédicaux de l’AP-HP
- Garantir l’excellence des travaux financés par la Fondation
Chaque année, le Conseil scientifique porte deux événements emblématiques de la Fondation de l’AP-HP :
- La Conférence scientifique — Un rendez-vous annuel dédié à la diffusion des connaissances scientifiques. Elle met à l’honneur un scientifique international de renom, invité à présenter son parcours, ses travaux et les avancées majeures liées à une thématique de pointe. Une intervention approfondie et accessible, conçue pour favoriser la compréhension des grands enjeux scientifiques contemporains.
- Les Prix Scientifiques — Ces Prix ont vocation à reconnaître et valoriser les travaux de recherche conduits par les professionnels médicaux et paramédicaux de l’AP-HP, toutes disciplines confondues. Ils récompensent les auteurs d’avancées scientifiques déterminantes pour l’avenir de la médecine et l’amélioration de la prise en charge des patients.
Conditions de candidature
Les candidatures sont ouvertes aux personnalités répondant aux critères suivants :
- Être titulaire d’un PhD ou équivalent
- Être membre ou ancien membre d’une unité de recherche
- Être extérieur(e) à la Fondation de l’AP-HP (à l’exception des membres du Conseil scientifique actuel arrivant au terme de leur premier mandat dont la candidature est éligible)
La procédure de candidature est identique pour une première candidature et pour un renouvellement de mandat.
Constitution du dossier de candidature
Le dossier complet comprend les éléments suivants :
- Un curriculum vitae intégrant le cursus hospitalier, universitaire et de recherche, les diplômes obtenus, l’activité actuelle et l’unité de recherche d’affectation
- La participation à une instance d’évaluation scientifique : mention oui/non, avec précision des instances concernées le cas échéant
- La liste des cinq réalisations scientifiques les plus remarquables
- Une lettre de motivation (500 mots maximum)
- Un engagement de disponibilité pour participer aux activités du Conseil scientifique
Modalités de dépôt et calendrier
Les dossiers sont à adresser par voie électronique, à l’adresse suivante : direction@fondation-aphp.fr, au plus tard le 31 mai 2026.
Chaque dossier donnera lieu à un accusé de réception, garantissant la prise en compte de la candidature.
Les candidatures seront examinées par un jury présidé par le Directeur général de l’AP-HP ou son représentant, composé du Président de la CME de l’AP-HP, du Vice-président recherche du directoire de l’AP-HP, du Président de la conférence des doyens ou son représentant, d’une à deux personnalités scientifiques externes, du Directeur de la DRCI et de la Directrice de la Fondation de l’AP-HP.
Les nouvelles nominations seront soumises à la délibération du Conseil d’administration de la Fondation de l’AP-HP lors de sa séance du 19 juin 2026.
Pour toute question relative à la procédure, contactez la direction de la Fondation de l’AP-HP à l’adresse : direction@fondation-aphp.fr